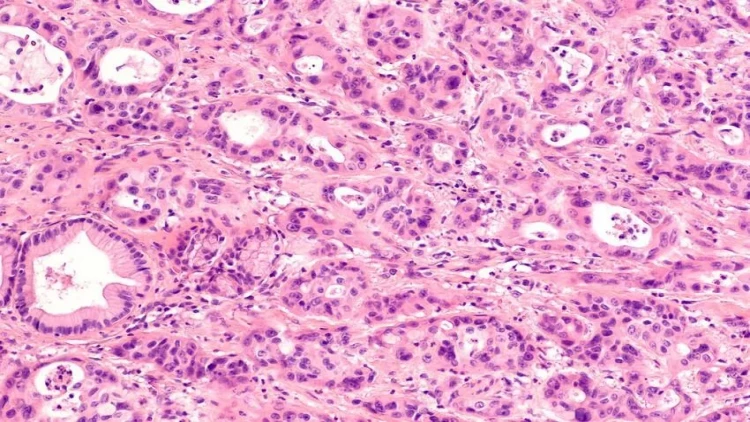
Xərçəngin inkişafına səbəb olan iki vitamin açıqlandı

Xərçəngin inkişafına səbəb olan iki vitamin açıqlandı
Karolinska Universitetinin (İsveç) alimləri müəyyən ediblər ki, insan bədənində C və E vitaminlərinin çox olması ağciyər xərçənginin inkişafına təkan verə bilər.
meqale.com report-a istinadən xəbər verir ki, araşdırmanın nəticələri The Journal of Clinical Investigation (JCI) jurnalında dərc olunub.
Tədqiqatın müəllifləri antioksidantların gəmiricilərin orqanizminə təsirini öyrəniblər. Antioksidantlar orqanizmdə oksidləşdirici proseslərlə mübarizə aparan molekullardır. Məlumdur ki, C və E vitaminlərinin tərkibində bu maddələrin böyük miqdarı mövcuddur.
Məlum olub ki, onların yüksək tərkibi daimi qan tədarükünə ehtiyacı olan şişlər də daxil olmaqla yeni qan damarlarının böyüməsinə səbəb olur. Bu da öz növbəsində qanda olan oksigenlə xərçəngli böyümələri qidalandırır və onlar şişməyə başlayırlar.
Tədqiqatçılar siçanlar üzərində daha bir neçə təcrübə aparıblar ki, bu da yalnız nəticələri təsdiqləyib. Məlum olduğu kimi, şişlərin böyümə sürəti antioksidantların dozasının artması ilə birbaşa mütənasibdir. Mütəxəssislərin fikrincə, bu, vitaminlərin həddindən artıq istehlakının təhlükəsindən xəbər verir.













